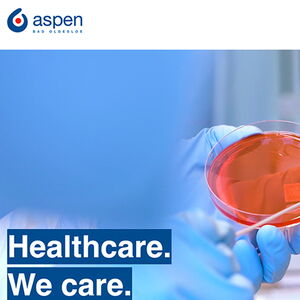

Alles, außer
gewöhnlich.
Seit 1999 realisieren wir werberelevante Inhalte für Kund:innen und trotzdem haben wir uns dagegen entschieden, hier ein historisches Archiv zu eröffnen. Stattdessen veröffentlichen wir hier lieber ein paar Highlights am Puls der Zeit.